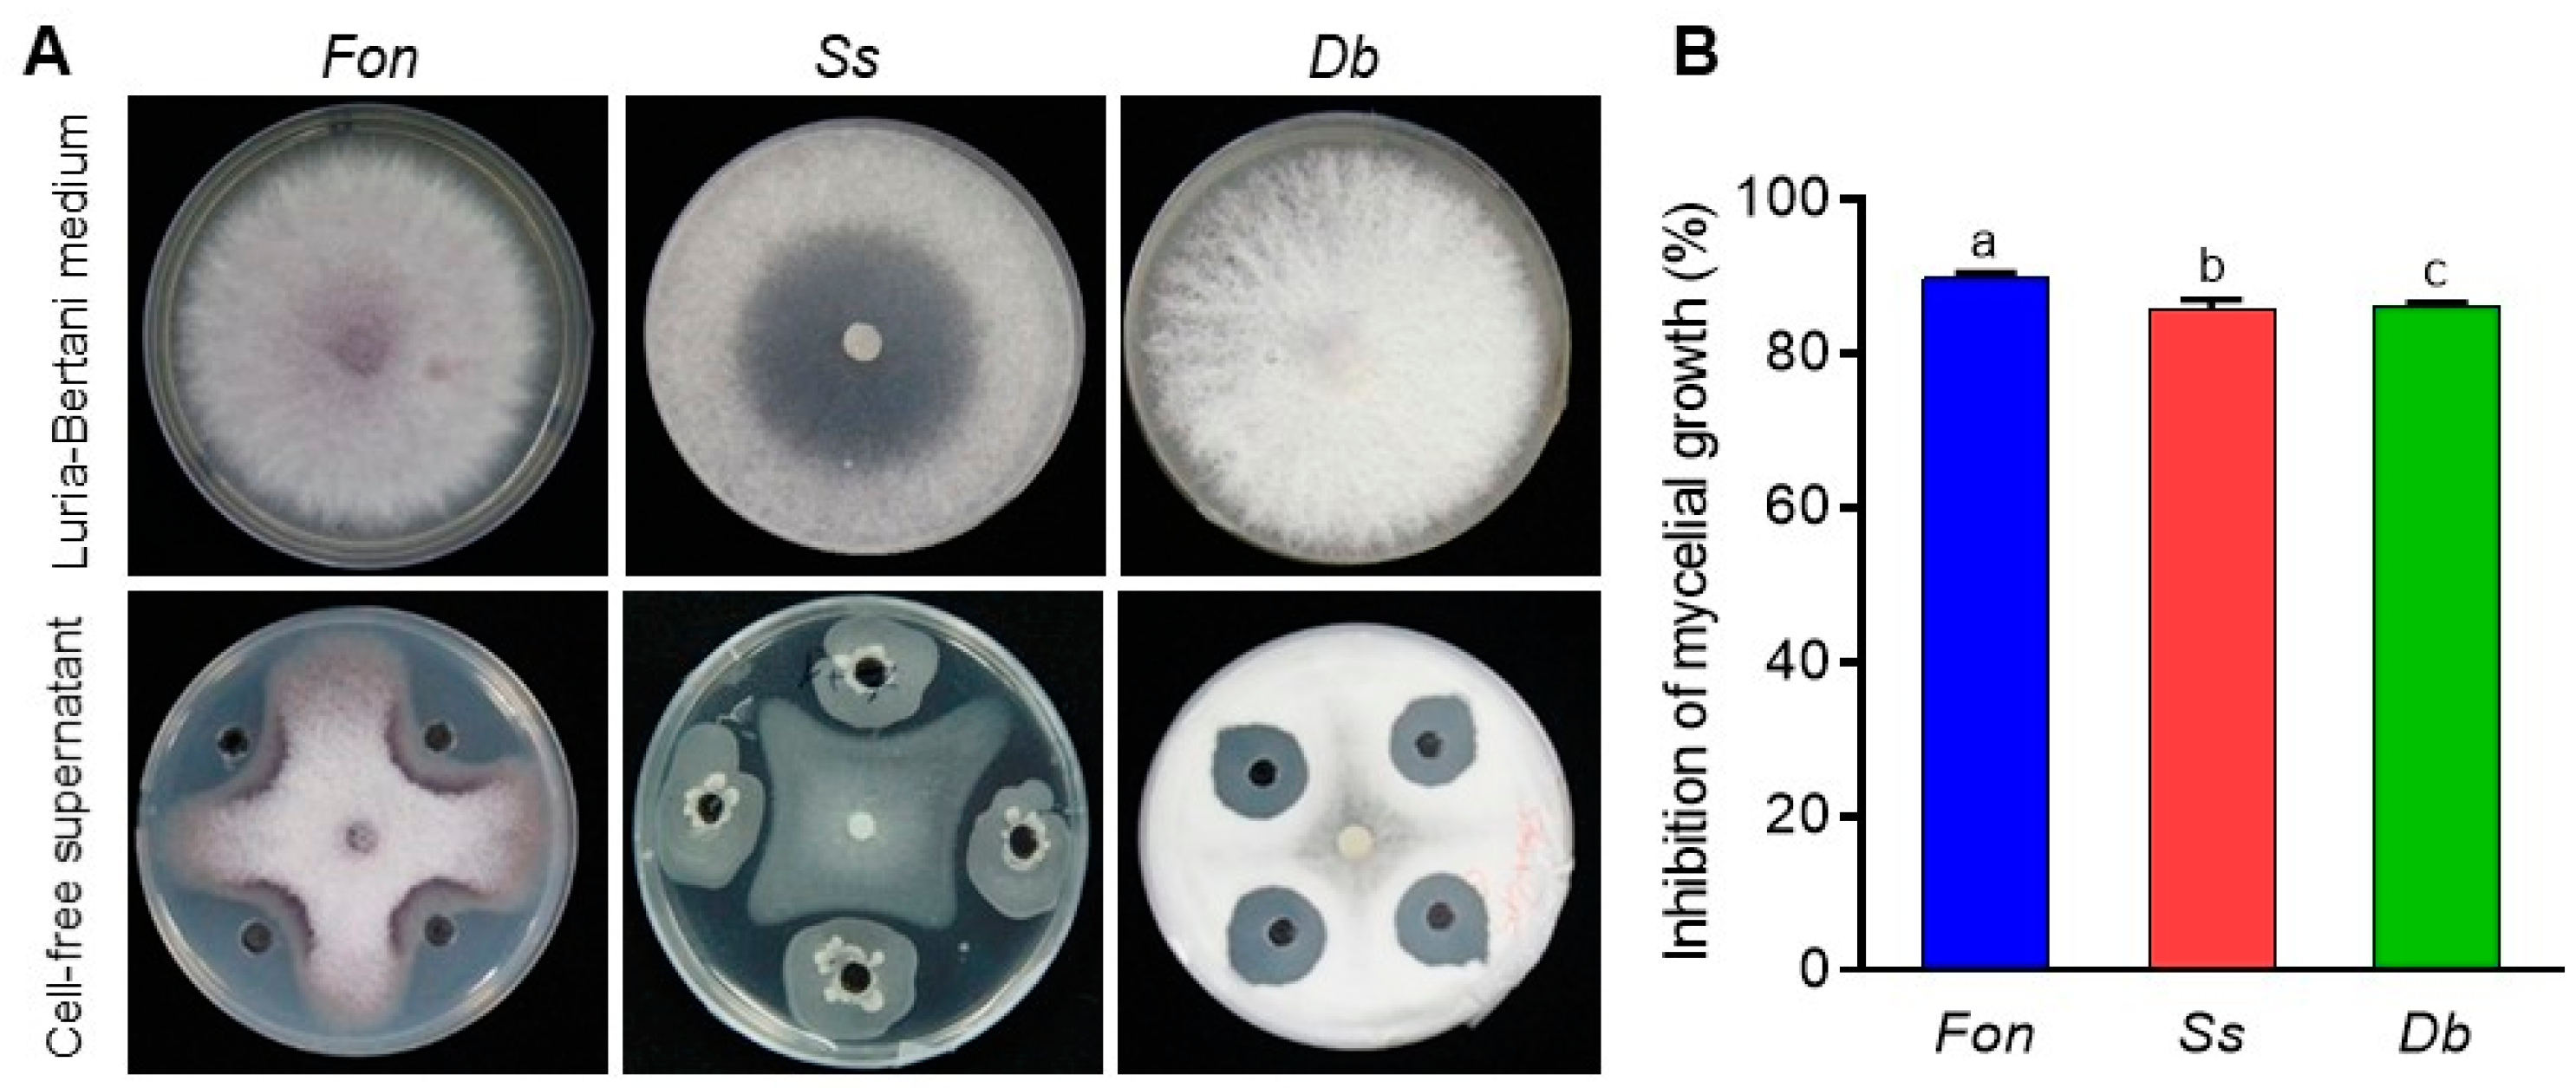
Jof 09 00797 g004

The Extracellular Lipopeptides and Volatile Organic Compounds of Bacillus subtilis DHA41 Display Broad-Spectrum Antifungal Activity against Soil-Borne Phytopathogenic Fungi
Abstract
1. Introduction
2. Materials and Methods
2.1. Growth Conditions for Bacterial Strain DHA41 and Fungal Pathogens
2.2. Amplification of 16S rRNA and Lipopeptide Biosynthesis Genes
2.3. Characterization of Cellular Fatty Acids
2.4. Extraction, Purification, and Characterization of Extracellular Lipopeptides from DHA41
2.5. Evaluation of Emulsification Index
2.6. Antifungal Activity of Cell-Free Supernatant, Lipopeptide Extract, and VOCs of DHA41
2.7. Minimal Inhibitory Concentration Assay
2.8. Microscopic Observation
2.9. Statistical Analysis
3. Results
3.1. Molecular and Biochemical Characterization of B. subtilis DHA41
3.2. Identification of Extracellular Lipopeptides Produced by B. subtilis DHA41
3.3. Antifungal Effect of Cell-Free Filtrate and Extracellular Lipopeptides of B. subtilis DHA41
3.4. Extracellular Lipopeptides Disrupt Fon Cellular Integrity
3.5. Antifungal Effect of the VOCs of B. subtilis DHA41
4. Discussion
5. Conclusions
Author Contributions
Funding
Institutional Review Board Statement
Informed Consent Statement
Data Availability Statement
Conflicts of Interest
References
- Coque, J.J.R.; Álvarez-Pérez, J.M.; Cobos, R.; González-García, S.; Ibáñez, A.M.; Diez Galán, A.; Calvo-Peña, C. Advances in the control of phytopathogenic fungi that infect crops through their root system. Adv. Appl. Microbiol. 2020, 111, 123–170. [Google Scholar]
- Gordon, T.R. Fusarium oxysporum and the Fusarium wilt syndrome. Annu. Rev. Phytopathol. 2017, 55, 23–39. [Google Scholar] [CrossRef] [PubMed]
- Lü, G.; Guo, S.; Zhang, H.; Geng, L.; Song, F.; Fei, Z.; Xu, Y. Transcriptional profiling of watermelon during its incompatible interaction with Fusarium oxysporum f. sp. niveum. Eur. J. Plant Pathol. 2011, 131, 585–601. [Google Scholar] [CrossRef]
- Mazzola, M.; Freilich, S. Prospects for biological soilborne disease control: Application of indigenous versus synthetic microbiomes. Phytopathology 2017, 107, 256–263. [Google Scholar] [CrossRef] [PubMed]
- Bonaterra, A.; Badosa, E.; Daranas, N.; Francés, J.; Roselló, G.; Montesinos, E. Bacteria as biological control agents of plant diseases. Microorganisms 2022, 10, 1759. [Google Scholar] [CrossRef]
- Khan, A.R.; Mustafa, A.; Hyder, S.; Valipour, M.; Rizvi, Z.F.; Gondal, A.S.; Yousuf, Z.; Iqbal, R.; Daraz, U. Bacillus spp. as bioagents: Uses and application for sustainable agriculture. Biology 2022, 11, 1763. [Google Scholar] [CrossRef]
- Blake, C.; Christensen, M.N.; Kovács, Á.T. Molecular aspects of plant growth promotion and protection by Bacillus subtilis. Mol. Plant-Microbe Interact. 2021, 34, 15–25. [Google Scholar] [CrossRef]
- Hashem, A.; Tabassum, B.; Fathi Abd Allah, E. Bacillus subtilis: A plant-growth promoting rhizobacterium that also impacts biotic stress. Saudi J. Biol. Sci. 2019, 26, 1291–1297. [Google Scholar] [CrossRef]
- Luo, L.; Zhao, C.; Wang, E.; Raza, A.; Yin, C. Bacillus amyloliquefaciens as an excellent agent for biofertilizer and biocontrol in agriculture: An overview for its mechanisms. Microbiol. Res. 2022, 259, 127016. [Google Scholar] [CrossRef]
- Baard, V.; Bakare, O.O.; Daniel, A.I.; Nkomo, M.; Gokul, A.; Keyster, M.; Klein, A. Biocontrol potential of Bacillus subtilis and Bacillus tequilensis against four Fusarium species. Pathogens 2023, 12, 254. [Google Scholar] [CrossRef]
- Rafiee, F.; Reza Fazeli, M.; Akhavan Sepahi, A.; Noormohammadi, Z. Isolation, screening and identification of native and new Bacillus subtilis with strong antifungal compound against Fusarium oxysporum. Biocontrol Sci. 2022, 27, 201–208. [Google Scholar] [CrossRef]
- Xu, W.; Yang, Q.; Yang, F.; Xie, X.; Goodwin, P.H.; Deng, X.; Tian, B.; Yang, L. Evaluation and genome analysis of Bacillus subtilis YB-04 as a potential biocontrol agent against Fusarium wilt and growth promotion agent of cucumber. Front. Microbiol. 2022, 13, 885430. [Google Scholar] [CrossRef]
- Luo, Y.; Sun, L.; Zhu, Z.; Ran, W.; Shen, Q. Identification and characterization of an anti-fungi Fusarium oxysporum f. sp. cucumerium protease from the Bacillus subtilis strain N7. J. Microbiol. 2013, 51, 359–366. [Google Scholar]
- Cheng, Y.; Gao, X.; He, H.; Zhang, X.; Wang, R.; Liu, J. Dual RNA sequencing analysis of Bacillus amyloliquefaciens and Sclerotinia sclerotiorum during infection of soybean seedlings by S. sclerotiorum unveils antagonistic interactions. Front. Microbiol. 2022, 13, 924313. [Google Scholar] [CrossRef]
- Huang, Y.; Wu, Z.; He, Y.; Ye, B.C.; Li, C. Rhizospheric Bacillus subtilis exhibits biocontrol effect against Rhizoctonia solani in pepper (Capsicum annuum). Biomed. Res. Int. 2017, 2017, 9397619. [Google Scholar] [CrossRef]
- Al-Mutar, A.M.A.; Abduljaleel, N.S.; Noman, M.; Azizullah; Li, D.; Song, F. Suppression of Fusarium wilt in watermelon by Bacillus amyloliquefaciens DHA55 through extracellular production of antifungal lipopeptides. J. Fungi 2023, 9, 336. [Google Scholar] [CrossRef]
- Khan, N.; Maymon, M.; Hirsch, A.M. Combating Fusarium infection using Bacillus-based antimicrobials. Microorganisms 2017, 5, 75. [Google Scholar] [CrossRef] [PubMed]
- Fan, H.; Li, S.; Zeng, L.; He, P.; Xu, S.; Bai, T.; Huang, Y.; Guo, Z.; Zheng, S.J. Biological control of Fusarium oxysporum f. sp. cubense tropical race 4 using natively isolated Bacillus spp. YN0904 and YN1419. J. Fungi 2021, 7, 795. [Google Scholar] [CrossRef] [PubMed]
- Jiang, C.H.; Yao, X.F.; Mi, D.D.; Li, Z.J.; Yang, B.Y.; Zheng, Y.; Qi, Y.J.; Guo, J.H. Comparative transcriptome analysis reveals the biocontrol mechanism of Bacillus velezensis F21 against Fusarium wilt on watermelon. Front. Microbiol. 2019, 10, 652. [Google Scholar] [CrossRef] [PubMed]
- Karthika, S.; Remya, M.; Varghese, S.; Dhanraj, N.D.; Sali, S.; Rebello, S.; Jose, S.M.; Jisha, M.S. Bacillus tequilensis PKDN31 and Bacillus licheniformis PKDL10 -As double headed swords to combat Fusarium oxysporum f. sp. lycopersici induced tomato wilt. Microb. Pathog. 2022, 172, 105784. [Google Scholar] [CrossRef]
- Planchon, A.; Durambur, G.; Besnier, J.B.; Plasson, C.; Gügi, B.; Bernard, S.; Mérieau, A.; Trouvé, J.P.; Dubois, C.; Laval, K.; et al. Effect of a Bacillus subtilis strain on flax protection against Fusarium oxysporum and its impact on the root and stem cell walls. Plant Cell Environ. 2021, 44, 304–322. [Google Scholar] [CrossRef] [PubMed]
- Swain, R.C.; Ray, R.C.; Nautiyal, C.S. Biocontrol efficacy of Bacillus subtilis strains isolated from cow dung against postharvest yam (Dioscorea rotundata L.) pathogens. Curr. Microbiol. 2008, 57, 407–411. [Google Scholar] [CrossRef] [PubMed]
- Essghaier, B.; Zouaoui, M.; Najjari, A.; Sadfi, N. Potentialities and characterization of an antifungal chitinase produced by a halotolerant Bacillus licheniformis. Curr. Microbiol. 2021, 78, 513–521. [Google Scholar] [CrossRef] [PubMed]
- Pazarlar, S.; Madriz-Ordeñana, K.; Thordal-Christensen, H. Bacillus cereus EC9 protects tomato against Fusarium wilt through JA/ET-activated immunity. Front. Plant Sci. 2022, 13, 1090947. [Google Scholar] [CrossRef] [PubMed]
- Ramírez, V.; Martínez, J.; Bustillos-Cristales, M.D.R.; Catañeda-Antonio, D.; Munive, J.A.; Baez, A. Bacillus cereus MH778713 elicits tomato plant protection against Fusarium oxysporum. J. Appl. Microbiol. 2022, 132, 470–482. [Google Scholar] [CrossRef] [PubMed]
- Sun, Y.; Huang, B.; Cheng, P.; Li, C.; Chen, Y.; Li, Y.; Zheng, L.; Xing, J.; Dong, Z.; Yu, G. Endophytic Bacillus subtilis TR21 improves banana plant resistance to Fusarium oxysporum f. sp. cubense and promotes root growth by upregulating the jasmonate and brassinosteroid biosynthesis pathways. Phytopathology 2022, 112, 219–231. [Google Scholar] [CrossRef]
- Jinal, N.H.; Amaresan, N. Evaluation of biocontrol Bacillus species on plant growth promotion and systemic-induced resistant potential against bacterial and fungal wilt-causing pathogens. Arch. Microbiol. 2020, 202, 1785–1794. [Google Scholar] [CrossRef]
- Akram, W.; Anjum, T.; Ali, B.; Ahmad, A. Screening of native bacillus strains to induce systemic resistance in tomato plants against fusarium wilt in split root system and its field applications. Int. J. Agric. Biol. 2013, 15, 1289–1294. [Google Scholar]
- Ongena, M.; Jacques, P. Bacillus lipopeptides: Versatile weapons for plant disease biocontrol. Trends Microbiol. 2008, 16, 115–125. [Google Scholar] [CrossRef]
- Caulier, S.; Nannan, C.; Gillis, A.; Licciardi, F.; Bragard, C.; Mahillon, J. Overview of the antimicrobial compounds produced by members of the Bacillus subtilis group. Front. Microbiol. 2019, 10, 302. [Google Scholar] [CrossRef]
- Penha, R.O.; Vandenberghe, L.P.S.; Faulds, C.; Soccol, V.T.; Soccol, C.R. Bacillus lipopeptides as powerful pest control agents for a more sustainable and healthy agriculture: Recent studies and innovations. Planta 2020, 251, 70. [Google Scholar] [CrossRef]
- Poulaki, E.G.; Tjamos, S.E. Bacillus species: Factories of plant protective volatile organic compounds. J. Appl. Microbiol. 2023, 134, lxad037. [Google Scholar] [CrossRef]
- Rani, A.; Rana, A.; Dhaka, R.K.; Singh, A.P.; Chahar, M.; Singh, S.; Nain, L.; Singh, K.P.; Minz, D. Bacterial volatile organic compounds as biopesticides, growth promoters and plant-defense elicitors: Current understanding and future scope. Biotechnol. Adv. 2023, 63, 108078. [Google Scholar] [CrossRef]
- de Boer, W.; Li, X.; Meisner, A.; Garbeva, P. Pathogen suppression by microbial volatile organic compounds in soils. FEMS Microbiol. Ecol. 2019, 95, fiz105. [Google Scholar] [CrossRef] [PubMed]
- Almeida, O.A.C.; de Araujo, N.O.; Dias, B.H.S.; de Sant’Anna Freitas, C.; Coerini, L.F.; Ryu, C.M.; de Castro Oliveira, J.V. The power of the smallest: The inhibitory activity of microbial volatile organic compounds against phytopathogens. Front. Microbiol. 2023, 13, 951130. [Google Scholar] [CrossRef]
- Wang, K.; Wang, Z.; Xu, W. Induced oxidative equilibrium damage and reduced toxin synthesis in Fusarium oxysporum f. sp. niveum by secondary metabolites from Bacillus velezensis WB. FEMS Microbiol. Ecol. 2022, 98, fiac080. [Google Scholar] [CrossRef] [PubMed]
- Moreno-Velandia, C.A.; Ongena, M.; Cotes, A.M. Effects of fengycins and iturins on Fusarium oxysporum f. sp. physali and root colonization by Bacillus velezensis Bs006 protect golden berry against vascular wilt. Phytopathology 2021, 111, 2227–2237. [Google Scholar] [CrossRef] [PubMed]
- Wang, J.; Qiu, J.; Yang, X.; Yang, J.; Zhao, S.; Zhou, Q.; Chen, L. Identification of lipopeptide produced by Bacillus amyloliquefaciens NCPSJ7 and its antifungal activities against Fusarium oxysporum f. sp. niveum. Foods 2022, 11, 2996. [Google Scholar] [CrossRef]
- Kang, B.R.; Park, J.S.; Jung, W.J. Antifungal evaluation of fengycin isoforms isolated from Bacillus amyloliquefaciens PPL against Fusarium oxysporum f. sp. lycopersici. Microb. Pathog. 2020, 149, 104509. [Google Scholar] [CrossRef]
- Wu, J.J.; Huang, J.W.; Deng, W.L. Phenylacetic acid and methylphenyl acetate from the biocontrol bacterium Bacillus mycoides BM02 suppress spore germination in Fusarium oxysporum f. sp. lycopersici. Front. Microbiol. 2020, 11, 569263. [Google Scholar] [CrossRef]
- Massawe, V.C.; Hanif, A.; Farzand, A.; Mburu, D.K.; Ochola, S.O.; Wu, L.; Tahir, H.A.S.; Gu, Q.; Wu, H.; Gao, X. Volatile compounds of endophytic Bacillus spp. have biocontrol activity against Sclerotinia sclerotiorum. Phytopathology 2018, 108, 1373–1385. [Google Scholar] [CrossRef] [PubMed]
- Yuan, J.; Raza, W.; Shen, Q.; Huang, Q. Antifungal activity of Bacillus amyloliquefaciens NJN-6 volatile compounds against Fusarium oxysporum f. sp. cubense. Appl. Environ. Microbiol. 2012, 78, 5942–5944. [Google Scholar] [CrossRef]
- Minerdi, D.; Bossi, S.; Gullino, M.L.; Garibaldi, A. Volatile organic compounds: A potential direct long-distance mechanism for antagonistic action of Fusarium oxysporum strain MSA 35. Environ. Microbiol. 2009, 11, 844–854. [Google Scholar] [CrossRef] [PubMed]
- Everts, K.L.; Himmelstein, J.C. Fusarium wilt of watermelon: Towards sustainable management of a re-emerging plant disease. Crop Prot. 2015, 73, 93–99. [Google Scholar] [CrossRef]
- Martyn, R.D. Fusarium wilt of watermelon: 120 years of research. Hortic. Rev. 2014, 42, 349–442. [Google Scholar]
- Thompson, J.D.; Gibson, T.J.; Plewniak, F.; Jeanmougin, F.; Higgins, D.G. The CLUSTAL_X windows interface: Flexible strategies for multiple sequence alignment aided by quality analysis tools. Nucleic Acids Res. 1997, 25, 4876–4882. [Google Scholar] [CrossRef]
- Tamura, K.; Stecher, G.; Kumar, S. MEGA11: Molecular evolutionary genetics analysis version 11. Mol. Biol. Evol. 2021, 38, 3022–3027. [Google Scholar] [CrossRef]
- Li, B.; Xu, L.; Lou, M.; Li, F.; Zhang, Y.; Xie, G.J. Isolation and characterization of antagonistic bacteria against bacterial leaf spot of Euphorbia pulcherrima. Lett. Appl. Microbiol. 2008, 46, 450–455. [Google Scholar] [CrossRef] [PubMed]
- Cao, Y.; Xu, Z.; Ling, N.; Yuan, Y.; Yang, X.; Chen, L.; Shen, B.; Shen, Q. Isolation and identification of lipopeptides produced by B. subtilis SQR9 for suppressing Fusarium wilt of cucumber. Sci. Hortic. 2012, 135, 32–39. [Google Scholar] [CrossRef]
- Sasser, M. Identification of Bacteria by Gas Chromatography of Cellular Fatty Acids; MIDI Technical Note 101; MIDI Inc.: Newark, DE, USA, 1990. [Google Scholar]
- Ayed, H.B.; Hmidet, N.; Béchet, M.; Chollet, M.; Chataigné, G.; Leclère, V.; Jacques, P.; Nasri, M. Identification and biochemical characteristics of lipopeptides from Bacillus mojavensis A21. Process Biochem. 2014, 49, 1699–1707. [Google Scholar] [CrossRef]
- Ali, N.; Wang, F.; Xu, B.; Safdar, B.; Ullah, A.; Naveed, M.; Wang, C.; Rashid, M.T. Production and application of biosurfactant produced by Bacillus licheniformis Ali5 in enhanced oil recovery and motor oil removal from contaminated sand. Molecules 2019, 24, 4448. [Google Scholar] [CrossRef] [PubMed]
- Xu, W.; Wang, H.; Lv, Z.; Shi, Y.; Wang, Z. Antifungal activity and functional components of cell-free supernatant from Bacillus amyloliquefaciens LZN01 inhibit Fusarium oxysporum f. sp. niveum growth. Biotechnol. Biotechnol. Equip. 2019, 33, 1042–1052. [Google Scholar] [CrossRef]
- Wang, Y.; Sun, Y.; Zhang, Y.; Zhang, X.; Feng, J. Antifungal activity and biochemical response of cuminic acid against Phytophthora capsici Leonian. Molecules 2016, 21, 756. [Google Scholar] [CrossRef]
- Gao, Z.; Zhang, B.; Liu, H.; Han, J.; Zhang, Y. Identification of endophytic Bacillus velezensis ZSY-1 strain and antifungal activity of its volatile compounds against Alternaria solani and Botrytis cinerea. Biol. Control 2017, 105, 27–39. [Google Scholar] [CrossRef]
- Gong, A.D.; Li, H.P.; Yuan, Q.S.; Song, X.S.; Yao, W.; He, W.J.; Zhang, J.B.; Liao, Y.C. Antagonistic mechanism of iturin A and plipastatin A from Bacillus amyloliquefaciens S76-3 from wheat spikes against Fusarium graminearum. PLoS ONE 2015, 10, e0116871. [Google Scholar] [CrossRef]
- Azizullah; Noman, M.; Gao, Y.; Wang, H.; Xiong, X.; Wang, J.; Li, D.; Song, F. The SUMOylation pathway components are required for vegetative growth, asexual development, cytotoxic responses, and programmed cell death events in Fusarium oxysporum f. sp. niveum. J. Fungi 2023, 9, 94. [Google Scholar] [CrossRef] [PubMed]
- Noman, M.; Ahmed, T.; Ijaz, U.; Shahid, M.; Nazir, M.M.; Azizullah; White, J.C.; Li, D.; Song, F. Bio-functionalized manganese nanoparticles suppress Fusarium wilt in watermelon (Citrullus lanatus L.) by infection disruption, host defense response potentiation, and soil microbial community modulation. Small 2023, 19, e2205687. [Google Scholar] [CrossRef]
- Kampfer, P. Limits and possibilities of total fatty acid analysis for classification and identification of Bacillus species. Syst. Appl. Microbiol. 1994, 17, 86–98. [Google Scholar] [CrossRef]
- Alamer, I.S.A.; Tomah, A.A.; Li, B.; Zhang, J.-Z. Isolation, identification and characterization of rhizobacteria strains for biological control of bacterial wilt (Ralstonia solanacearum) of eggplant in China. Agriculture 2020, 10, 37. [Google Scholar] [CrossRef]
- Gu, Q.; Yang, Y.; Yuan, Q.; Shi, G.; Wu, L.; Lou, Z.; Huo, R.; Wu, H.; Borriss, R.; Gao, X. Bacillomycin D produced by Bacillus amyloliquefaciens is involved in the antagonistic interaction with the plant pathogenic fungus Fusarium graminearum. Appl. Environ. Microbiol. 2017, 83, e01075-17. [Google Scholar] [CrossRef]
- Zhao, P.C.; Quan, C.S.; Wang, Y.G.; Wang, J.H.; Fan, S.D. Bacillus amyloliquefaciens Q-426 as a potential biocontrol agent against Fusarium oxysporum f. sp. spinaciae. J. Basic Microbiol. 2014, 54, 448–456. [Google Scholar] [CrossRef]
- Alabouvette, C.; Olivain, C.; Migheli, Q.; Steinberg, C. Microbiological control of soil-borne phytopathogenic fungi with special emphasis on wilt-inducing Fusarium oxysporum. New Phytol. 2009, 184, 529–544. [Google Scholar] [CrossRef]
- Ajilogba, C.F.; Babalola, O.O. Integrated management strategies for tomato Fusarium wilt. Biocontrol Sci. 2013, 18, 117–127. [Google Scholar] [CrossRef] [PubMed]
- Bubici, G.; Kaushal, M.; Prigigallo, M.I.; Gómez-Lama Cabanás, C.; Mercado-Blanco, J. Biological control agents against Fusarium wilt of banana. Front. Microbiol. 2019, 10, 616. [Google Scholar] [CrossRef] [PubMed]
- Zhang, X.; Xue, C.; Fang, D.; He, X.; Wei, M.; Zhuo, C.; Jin, J.; Shen, B.; Li, R.; Ling, N.; et al. Manipulating the soil microbiomes during a community recovery process with plant beneficial species for the suppression of Fusarium wilt of watermelon. AMB Express 2021, 11, 87. [Google Scholar] [CrossRef]
- Raza, W.; Yuan, J.; Ling, N.; Huang, Q.W.; Shen, Q.R. Production of volatile organic compounds by an antagonistic strain Paenibacillus polymyxa WR-2 in the presence of root exudates and organic fertilizer and their antifungal activity against Fusarium oxysporum f. sp. niveum. Biol. Control 2015, 80, 89–95. [Google Scholar] [CrossRef]
- Faheem, M.; Raza, W.; Zhong, W.; Nan, Z.; Shen, Q.; Xu, Y. Evaluation of the biocontrol potential of Streptomyces goshikiensis YCXU against Fusarium oxysporum f. sp. niveum. Biol. Control 2015, 81, 101–110. [Google Scholar] [CrossRef]
- Meyer, S.L.; Everts, K.L.; Gardener, B.M.; Masler, E.P.; Abdelnabby, H.M.E.; Skantar, A.M. Assessment of DAPG-producing Pseudomonas fluorescens for management of Meloidogyne incognita and Fusarium oxysporum on watermelon. J. Nematol. 2016, 48, 43–53. [Google Scholar] [CrossRef]
- Ge, B.; Liu, B.; Nwet, T.T.; Zhao, W.; Shi, L.; Zhang, K. Bacillus methylotrophicus strain NKG-1, isolated from Changbai Mountain, China, has potential applications as a biofertilizer or biocontrol agent. PLoS ONE 2016, 11, e0166079. [Google Scholar] [CrossRef] [PubMed]
- Xu, W.; Wang, K.; Wang, H.; Liu, Z.; Shi, Y.; Gao, Z.; Wang, Z. Evaluation of the biocontrol potential of Bacillus sp. WB against Fusarium oxysporum f. sp. niveum. Biol. Control 2020, 147, 104288. [Google Scholar] [CrossRef]
- Wang, H.; Wang, Z.; Liu, Z.; Wang, K.; Xu, W. Membrane disruption of Fusarium oxysporum f. sp. niveum induced by myriocin from Bacillus amyloliquefaciens LZN01. Microb. Biotechnol. 2021, 14, 517–534. [Google Scholar] [CrossRef]
- Wu, Y.; Zhou, J.; Li, C.; Ma, Y. Antifungal and plant growth promotion activity of volatile organic compounds produced by Bacillus amyloliquefaciens. Microbiologyopen 2019, 8, e00813. [Google Scholar] [CrossRef]
- Zhu, J.; Tan, T.; Shen, A.; Yang, X.; Yu, Y.; Gao, C.; Li, Z.; Cheng, Y.; Chen, J.; Guo, L.; et al. Biocontrol potential of Bacillus subtilis IBFCBF-4 against Fusarium wilt of watermelon. J. Plant Pathol. 2020, 102, 433–441. [Google Scholar] [CrossRef]
- Grubbs, K.J.; Bleich, R.M.; Santa Maria, K.C.; Allen, S.E.; Farag, S.; Shank, E.A.; Bowers, A.A. Large-scale bioinformatics analysis of Bacillus genomes uncovers conserved roles of natural products in bacterial physiology. mSystems 2017, 2, e00040-17. [Google Scholar] [CrossRef] [PubMed]
- Kiesewalter, H.T.; Lozano-Andrade, C.N.; Wibowo, M.; Strube, M.L.; Maróti, G.; Snyder, D.; Jørgensen, T.S.; Larsen, T.O.; Cooper, V.S.; Weber, T.; et al. Genomic and chemical diversity of Bacillus subtilis secondary metabolites against plant pathogenic fungi. mSystems 2021, 6, e00770-20. [Google Scholar] [CrossRef]
- Dunlap, C.A.; Bowman, M.J.; Rooney, A.P. Iturinic lipopeptide diversity in the Bacillus subtilis species group—Important antifungals for plant disease biocontrol applications. Front. Microbiol. 2019, 10, 1794. [Google Scholar] [CrossRef]
- Deepak, R.; Jayapradha, R. Lipopeptide biosurfactant from Bacillus thuringiensis pak2310: A potential antagonist against Fusarium oxysporum. J. Mycol. Med. 2015, 25, e15–e24. [Google Scholar] [CrossRef]
- Nayarisseri, A.; Singh, P.; Singh, S. Screening, isolation and characterization of biosurfactant producing Bacillus subtilis strain ANSKLAB03. Bioinformation 2018, 14, 304–314. [Google Scholar] [CrossRef] [PubMed]
- Ji, S.H.; Paul, N.C.; Deng, J.X.; Kim, Y.S.; Yun, B.S.; Yu, S.H. Biocontrol activity of Bacillus amyloliquefaciens CNU114001 against fungal plant diseases. Mycobiology 2013, 41, 234–242. [Google Scholar] [CrossRef]
- Hazarika, D.J.; Goswami, G.; Gautom, T.; Parveen, A.; Das, P.; Barooah, M.; Boro, R.C. Lipopeptide mediated biocontrol activity of endophytic Bacillus subtilis against fungal phytopathogens. BMC Microbiol. 2019, 19, 71. [Google Scholar] [CrossRef]
- Luo, S.; Wang, H.; Wang, Z.; Xu, W.; Tian, R.; Zhou, J. Internalization of myriocin involved in energy and affected expression of genes and proteins in the endocytosis pathway in Fusarium oxysporum f. sp. niveum. Biotechnol. Biotechnol. Equip. 2022, 36, 520–532. [Google Scholar] [CrossRef]
- Wang, H.; Wang, Z.; Xu, W.; Wang, K. Comprehensive transcriptomic and proteomic analyses identify intracellular targets for myriocin to induce Fusarium oxysporum f. sp. niveum cell death. Microb. Cell Fact. 2021, 20, 69. [Google Scholar] [CrossRef] [PubMed]
- Du, J.; Ji, Y.; Li, Y.; Liu, B.; Yu, Y.; Chen, D.; Li, Z.; Zhao, T.; Xu, X.; Chang, Q.; et al. Microbial volatile organic compounds 2-heptanol and acetoin control Fusarium crown and root rot of tomato. J. Cell Physiol. 2022. [Google Scholar] [CrossRef]
- Tahir, H.A.; Gu, Q.; Wu, H.; Raza, W.; Hanif, A.; Wu, L.; Colman, M.V.; Gao, X. Plant growth promotion by volatile organic compounds produced by Bacillus subtilis SYST2. Front. Microbiol. 2017, 8, 171. [Google Scholar] [CrossRef] [PubMed]

| Genes | Primers | Sequences (5′-3′) | Size (bp) | References |
|---|---|---|---|---|
| 16S rRNA | 27F | AGAGTTTGATCATGGCTCAG | 1081 | [48] |
| 1479R | TACGGTTACCTTGTTACGACTT | |||
| ItuB | BamB2F | CGACATACAGTTCTCCCCGGT | 461 | [49] |
| BamB2R | AAGAAGGCGTTTTTCAAGCA | |||
| ItuD | ItuD1F | GACGGTAGATTCGCTGCTGT | 583 | [49] |
| ItuD1R | TGATGCGATCTCCTTGGATG | |||
| FenD | FNDF2 | CTGGGAGGTCAGCCGGTCTG | 216 | [49] |
| FNDR2 | GTGGTCGCCGGTTCACAAAT |
| Fatty Acids (FA) | Content (%) |
|---|---|
| Saturated straight chain FA | |
| 12:0 | -- |
| 14:0 | 2.67 |
| 16:0 | 15.42 |
| 18:0 | 0.54 |
| Saturated terminally branched FA | |
| 13:0 iso | 0.51 |
| 14:0 iso | 1.55 |
| 15:0 iso | 24.55 |
| 16:0 iso | 1.79 |
| 17:0 iso | 6.65 |
| 15:0 anteso | 34.10 |
| 17:0 anteso | 5.20 |
| Monounsaturated FA | |
| 16:1 w11c | 4.06 |
| 17:1ω10c iso | 1.46 |
| Mineral Oil | Sunflower Oil | Toluene |
|---|---|---|
| 51 ± 0.50 | 31.25 ± 0.03 | nd |
Disclaimer/Publisher’s Note: The statements, opinions and data contained in all publications are solely those of the individual author(s) and contributor(s) and not of MDPI and/or the editor(s). MDPI and/or the editor(s) disclaim responsibility for any injury to people or property resulting from any ideas, methods, instructions or products referred to in the content. |
© 2023 by the authors. Licensee MDPI, Basel, Switzerland. This article is an open access article distributed under the terms and conditions of the Creative Commons Attribution (CC BY) license (https://creativecommons.org/licenses/by/4.0/).
Share and Cite
Al-Mutar, D.M.K.; Noman, M.; Alzawar, N.S.A.; Qasim, H.H.; Li, D.; Song, F. The Extracellular Lipopeptides and Volatile Organic Compounds of Bacillus subtilis DHA41 Display Broad-Spectrum Antifungal Activity against Soil-Borne Phytopathogenic Fungi. J. Fungi 2023, 9, 797. https://doi.org/10.3390/jof9080797
Al-Mutar DMK, Noman M, Alzawar NSA, Qasim HH, Li D, Song F. The Extracellular Lipopeptides and Volatile Organic Compounds of Bacillus subtilis DHA41 Display Broad-Spectrum Antifungal Activity against Soil-Borne Phytopathogenic Fungi. Journal of Fungi. 2023; 9(8):797. https://doi.org/10.3390/jof9080797
Chicago/Turabian StyleAl-Mutar, Dhabyan Mutar Kareem, Muhammad Noman, Noor Salih Abduljaleel Alzawar, Hadi Hussein Qasim, Dayong Li, and Fengming Song. 2023. "The Extracellular Lipopeptides and Volatile Organic Compounds of Bacillus subtilis DHA41 Display Broad-Spectrum Antifungal Activity against Soil-Borne Phytopathogenic Fungi" Journal of Fungi 9, no. 8: 797. https://doi.org/10.3390/jof9080797
APA StyleAl-Mutar, D. M. K., Noman, M., Alzawar, N. S. A., Qasim, H. H., Li, D., & Song, F. (2023). The Extracellular Lipopeptides and Volatile Organic Compounds of Bacillus subtilis DHA41 Display Broad-Spectrum Antifungal Activity against Soil-Borne Phytopathogenic Fungi. Journal of Fungi, 9(8), 797. https://doi.org/10.3390/jof9080797

